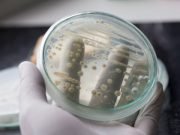
Yeast engineered to manufacture complex medicine Yeast engineered to manufacture complex medicine

Human-engineered changes on Mississippi River increased extreme floods
A new study has revealed for the first time the last 500-year flood history of the Mississippi River. It shows a dramatic rise in...
Prehistoric reptile pregnant with octuplets
Palaeontologists have discovered part of the skeleton of a 180 million-year-old pregnant ichthyosaur with the remains of between six and eight tiny embryos between...
Determining the timing of methanogen evolution
Early forms of life very likely had metabolisms that transformed the primordial Earth, such as initiating the carbon cycle and producing most of the...
Physicists zoom in on mysterious ‘missing’ antimatter
When the Universe arose some 13.7 billion years ago, the Big Bang generated matter and antimatter particles in mirroring pairs. So the reigning physics...
Yeast engineered to manufacture complex medicine
Stanford University bioengineers have figured out a way to make noscapine, a non-narcotic cough suppressant that occurs naturally in opium poppies, in brewer's yeast.
The...
Research shows first land plants were parasitised by microbes
Relationship between plants and filamentous microbes not only dates back millions of years, but modern plants have maintained this ancient mechanism to accommodate and...
Giant clue in the search for Earth 2.0
In a new study published today in the Astrophysical Journal, researchers from New York University Abu Dhabi and NASA's Jet Propulsion Laboratory (JPL) in...
New study suggests tens of thousands of black holes exist in Milky Way’s center
A Columbia University-led team of astrophysicists has discovered a dozen black holes gathered around Sagittarius A* (Sgr A*), the supermassive black hole in the...
Physicists demonstrate demixing behavior of rotating particles
Physicists from Friedrich-Alexander-Universität Erlangen-Nürnberg and Heinrich-Heine Universität Düsseldorf have demonstrated that demixing occurs in systems made up of macroscopic particles rotating in opposite directions...
Scientists create ‘Swiss army knife’ for electron beams
DESY scientists have created a miniature particle accelerator for electrons that can perform four different functions at the push of a button. The experimental...
Researchers develop nanoparticle films for high-density data storage
As we generate more and more data, the need for high-density data storage that remains stable over time is becoming critical. New nanoparticle-based films...